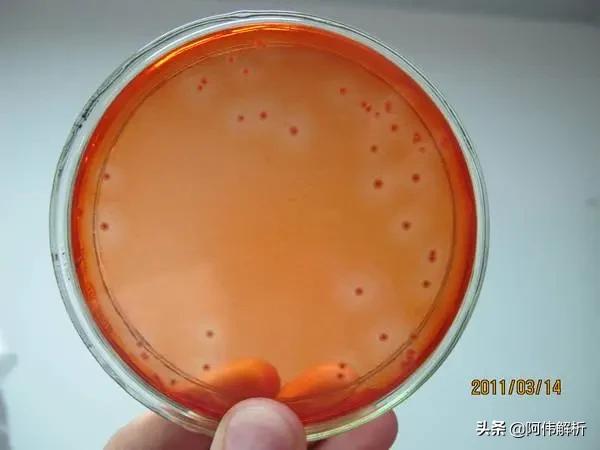
焰色反应实验报告简单,显色反应化学实验高中
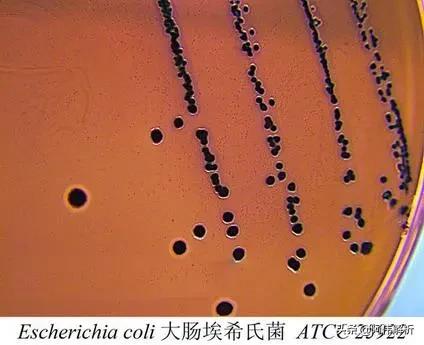
焰色反应实验报告简单,显色反应化学实验高中

高中生物实验各种显色反应小结
高中生物实验中涉及许多物质检测与鉴定的显色方法,其原理多种多样,不仅有利用氧化还原反应的原理也有利用络合物的特征等等。在生物实验中通常会通过一些颜色反应来判断某项物质的存在,但知识比较零散,不利于记忆和掌握。本文简单分析了高中生物实验中的"颜色",对相关知识进行整理,希望对高中生物学习有所帮助。
01
淀粉鉴定

〖试剂〗: 碘液
〖结果〗: 蓝色
〖原理〗: 淀粉能吸附碘,使碘吸收的可见光的波长向短的波长方向移动,棕色的碘液就变成蓝色。
〖注意〗: ①直链淀粉遇碘呈蓝色,支链淀粉遇碘呈紫红色。②碘液鉴定淀粉要在30℃及以下的情况进行。将装有淀粉溶液的试管分别放置在0℃至100℃等不同温度下观测,可发现:当温度30℃时,溶液仍呈现蓝色;当温度在40℃至50℃时,蓝色很快褪去;温度在60℃以上时,则不会出现蓝色。
〖应用〗: 光合作用的探究历程中德国植物学家萨克斯利用碘蒸气鉴定淀粉是光合作用的产物。
02
还原糖鉴定

〖试剂〗: 斐林试剂
〖结果〗: 砖红色沉淀
〖原理〗: 还原糖中的醛基(-CHO)在加热条件下能将Cu(OH)2中的铜离子还原成亚铜离子,从而生成砖红色的Cu2O沉淀物。
〖注意〗: ①斐林试剂的甲液和乙液要等量混合均匀后方可使用,而且是现用现配,条件需要水浴加热,当然化学上是直接将试管在火焰上加热,只不过考虑安全问题,水浴加热更安全,还能受热均匀。②注意与双缩脲试剂的浓度区别与使用区别。
〖应用〗: 检验和检测某糖是否为还原糖;不同生物组织中含糖量高低的测定;在医学上进行疾病的诊断,如糖尿病、肾炎。
03
脂肪鉴定

〖试剂〗: 苏丹Ⅲ或苏丹Ⅳ
〖结果〗: 苏丹Ⅲ+脂肪→橘黄色;苏丹Ⅳ+脂肪→红色
〖原理〗: 脂肪和苏丹染液有比较强的亲和力
〖注意〗: 脂肪的鉴定需要用显微镜观察。
〖应用〗: 检测食品中营养成分是否含有脂肪。
04
蛋白质鉴定

〖试剂〗: 双缩脲试剂
〖结果〗: 紫色
〖原理〗: 在碱性溶液NaOH中,双缩脲(H2NOC-NH-CONH2)能与Cu2+ 作用,形成紫色或紫色的络合物,这个反应叫双缩脲反应。由于蛋白质分子中含有很多与双缩脲结构相似的肽键,因此,蛋白质都可与双缩脲试剂发生颜色反应,从而用来鉴定蛋白质的存在。
〖注意〗: ①双缩脲试剂在使用时,先加A液再加B液,反应条件为常温(不需要加热)。②注意检测试剂为“双缩脲试剂“而非”双缩脲”③双缩脲试剂之所以能检测蛋白质,是因为蛋白质有肽键(实际上是含有与双缩脲类似的结构),双缩脲试剂能检测含有两个肽键及以上的物质,不能检测二肽和尿素。
〖应用〗: 鉴定某些消化液中含有蛋白质;用于劣质奶粉的鉴定。
05
DNA和RNA染色

〖试剂〗: 甲基绿和吡罗红(派洛宁)
〖结果〗: 甲基绿使DNA呈绿色,吡罗红使RNA呈红色
〖原理〗: 当甲基绿与吡罗红作为混合染料时,甲基绿与染色质中DNA选择性结合显示绿色或蓝色;吡罗红与核仁、细胞质中的RNA选择性结合显示红色。其原因可能是两种染料的混合染液中有竞争作用,同时两种核酸分子都是多聚体,而其聚合程度有所不同。甲基绿易与聚合程度高的DNA结合呈现绿色。而吡罗红则与聚合程度较低的RNA结合呈现红色。
〖注意〗: 甲基绿吡罗红最好混合使用
〖应用〗: 用于观察DNA和RNA在细胞中的分布
06
线粒体染色

〖试剂〗: 健那绿
〖结果〗: 蓝绿色
〖原理〗: 线粒体中细胞色素氧化酶使染料保持氧化状态(即有色状态)呈蓝绿色,而在周围的细胞质中染料被还原,成为无色状态。
〖注意〗: 健那绿染液是专一性染线粒体的活细胞染料。
〖应用〗: 可以在高倍显微镜下观察线粒体分布和形态规律。
07
细胞死活鉴定

〖试剂〗: 台盼蓝
〖结果〗: 蓝色
〖原理〗: 正常的活细胞,细胞膜结构完整具有选择透过性能够排斥台盼蓝,使之不能够进入胞内;死细胞或细胞膜不完整的细胞,胞膜的通透性增加,可被台盼蓝染成蓝色。
〖应用〗: 区分活细胞和死细胞;检测细胞膜的完整性。
08
染色体染色

〖试剂〗: 碱性染料( 醋酸洋红、龙胆紫、改良的苯酚品红染液)
〖结果〗: 醋酸洋红使染色体呈紫红色,龙胆紫使染色体呈紫色
〖注意〗: 虽然醋酸洋红、龙胆紫这两种颜料称做碱性染料,但其溶液呈酸性。碱性(或酸性)染色剂的界定并非由染料溶液的pH值决定的,而是根据染料物质中助色基团电离后所带的电荷来决定的。助色基团带正电荷的染色剂为碱性染色剂(又称阳离子染料),助色基团带负电荷的染色剂为酸性染色剂(又称阴离子染料)。
〖应用〗: 用于观察细胞有丝分裂过程中染色体形态、行为及数量变化。
09
酒精检测

〖试剂〗: 重铬酸钾
〖结果〗: 灰绿色
〖原理〗: 酸性重铬酸钾有强氧化性,更易将酒精氧化,生成的硫酸铬呈灰绿色。
K2Cr2O7+3C2H5OH+4H2SO4——
3CH3CHO(乙醛)+K2SO4+Cr2(SO4)3
+7H2O
〖注意〗: 橙色的重铬酸钾溶液在酸性条件下与酒精发生化学反应。
〖应用〗: 探究酵母菌细胞呼吸的方式;制作果酒时检验是否产生了酒精;检查司机是否酒后驾驶。
10
二氧化碳检测


〖试剂〗: 澄清的石灰水或溴麝香草酚蓝水溶液
〖结果〗: CO2可以使澄清的石灰水变混浊,也可使溴麝香草酚蓝水溶液由蓝变绿在变黄。
〖应用〗: 根据石灰水混浊程度或溴麝香草酚蓝水溶液变黄的时间长短,可以检测酵母菌培养液中CO2的产生情况。
11
亚硝酸盐含量的检测

〖试剂〗: 对氨基苯磺酸
〖结果〗: 玫瑰红
〖原理〗: 在盐酸酸化条件下,亚硝酸盐与对氨基苯磺酸发生重氮化反应后,与N-1-萘基乙胺盐酸盐结合形成玫瑰红色染料。
〖应用〗: 将显色反应后的样品与已知浓度的标准液进行目测比较,可以大致估算出泡菜中亚硝酸盐的含量。
12
DNA鉴定

〖试剂〗: 二苯胺
〖结果〗: 蓝色
〖原理〗: DNA分子中的脱氧核糖在酸性溶液中变成ω-羟基-γ-酮基戊糖,与二苯胺试剂作用生成蓝色化合物。化合物蓝色的深浅与DNA的含量成比例关系,可用比色法测定。
〖应用〗: 用于DNA的鉴定和DNA含量的定量检测
13
纤维素分解菌的筛选
〖试剂〗: 刚果红
〖结果〗: 红色
〖原理〗: 刚果红是一种染料,它可以与像纤维素这样的多糖物质形成红色复合物,但并不和水解后的纤维二糖和葡萄糖发生这种反应。当在含有纤维素的培养基中加入刚果红时,刚果红能与培养基中的纤维素形成红色复合物。当纤维素被纤维素分解菌分解后,刚果红-纤维素的复合物就无法形成,培养基中会出现以纤维素分解菌为中心的透明圈。
〖应用〗: 通过是否产生透明圈来筛选纤维素分解菌
14
大肠杆菌检测
〖试剂〗: 伊红美蓝
〖结果〗: 黑色
〖原理〗: 在伊红美蓝培养基上,大肠杆菌的代谢产物(有机酸)与伊红美蓝结合使菌落呈现黑色。
〖应用〗: 用滤膜法测定水中大肠杆菌的含量
15
筛选能分解尿素的细菌
〖试剂〗: 酚类指示剂
〖结果〗: 红色
〖原理〗: 在细菌分解尿素的化学反应中,细菌合成的脲酶可以将尿素分解成氨,氨会使培养基的碱性增强,使PH升高,从而使酚红指示剂变红。
〖应用〗: 在以尿素为唯一氮源的培养基加入酚红指示剂,培养某种细菌后,看指示剂变红与否可以鉴定这种细菌能否分解尿素。